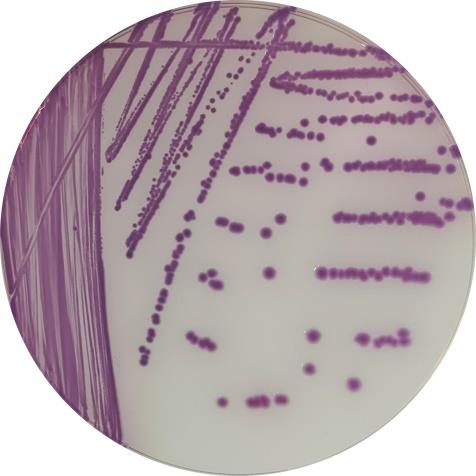

返回



英文名称
:产品货号
:HBJZDL020产品规格
:110-1100CFU/球*10支/盒产品价格
:2000元保质期
:一年产品用途
:该产品是一种含一定数量微生物的冻干品。作为定量的质量控制样本备注
:【包装规格】 110-1100CFU/球*10支/盒
【预期用途】 该产品是一种含一定数量微生物的冻干品。作为定量的质量控制样本。
【主要组成成份】 主要成分为菌种及冻干保护剂。
菌种来源:标准菌株的供应商是国际和国家菌种保藏中心,传代次数:≤4。
【储存条件及有效期】 -20℃及以下,有效期12个月
【使用方法】
1.平板涂布法:
(1)使用前将未开启的西林瓶平衡至室温。
(2)无菌操作打开定量菌株瓶塞,用移液器吸取1.1mL复溶液加入西林瓶中,盖上瓶塞,涡旋震荡5~10s,使小球完全溶解。
(3)用移液器吸取100 μL菌液至待检培养基和对照培养基,用涂布棒涂布均匀。
(4)将平板倒置,置于适宜的条件下培养。
2.液体接种或倾注平皿法:
(1)使用前将未开启的西林瓶平衡至室温。
(2)无菌操作打开定量菌株瓶塞,用移液器吸取1.1mL复溶液加入西林瓶中,盖上瓶塞,涡旋震荡5~10s,使小球完全溶解。
(3)用移液器吸取1mL菌液,加入9mL无菌生理盐水中,混匀。
(4)吸取上述菌液,加至待检液体培养基及计数或参比培养基中,置于适宜的条件下培养。或加至无菌空平皿中,注入15mL~20mL温度不超过46℃的已融化的待检培养基,混匀,待培养基凝固后,用5mL培养基覆盖,凝固后倒置培养。
乙型副伤寒沙门氏菌CMCC(B)50094(定量)鉴定结果:
1.XLD平板和沙门氏菌显色平板上的菌落特征:
XLD平板:为较大的黑色中心,几乎呈现全部黑色的菌落,结果如图1所示。
沙门氏菌显色平板:为紫色菌落,结果如图2所示。
![]() |
![]() |
|
图1 在XLD平板上的菌落特征 |
图2 在沙门氏菌显色平板上的菌落特征 |
2.革兰氏染色镜检:革兰氏阴性杆菌。
![]() |
|
图3 革兰氏染色镜检 |
3.博检革兰氏阴性细菌鉴定系统生化检测:沙门氏菌。
![]() |
|
图4 博检革兰氏阴性细菌鉴定系统生化检测结果 |
【产品性能指标】
该产品是一种含有一定数量微生物的冷冻干燥的水溶球。该球为白色近似球体。经培养应无杂菌生长。
【相关资料】
搜产品

在线咨询
在线购买